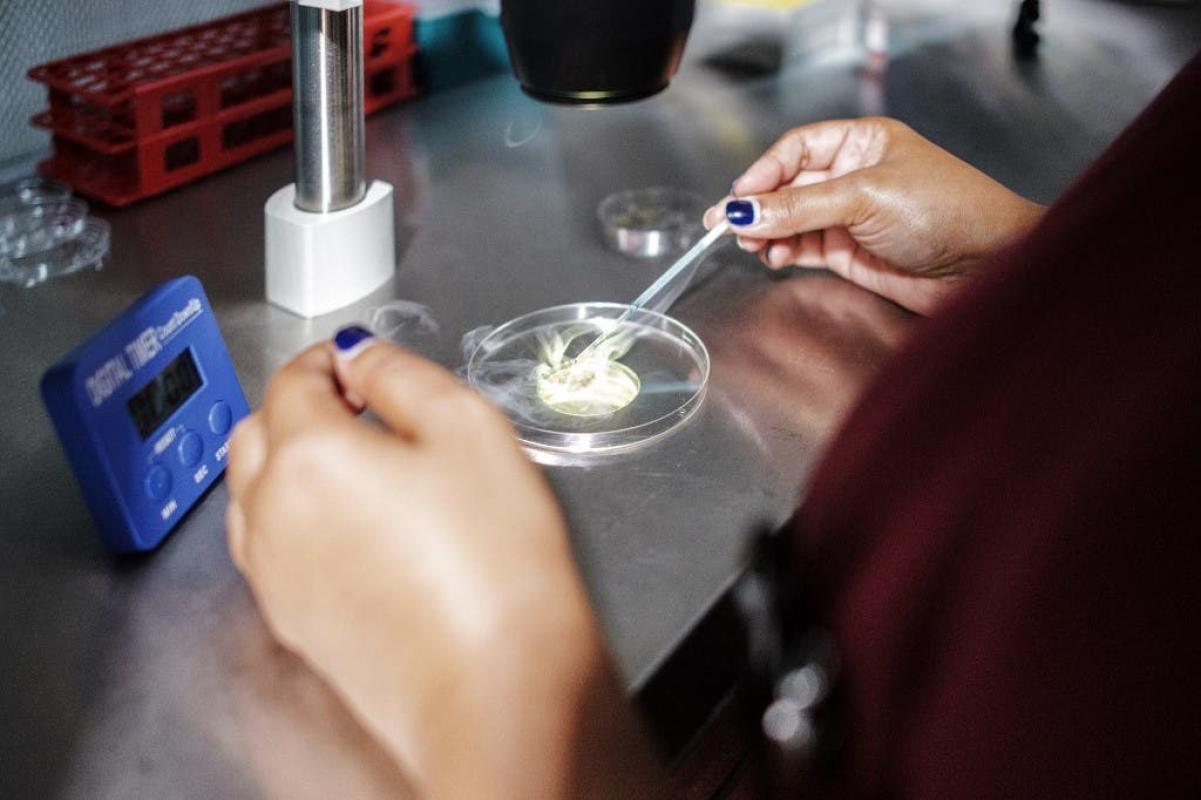

Dramático engaño: el terrible secreto que ocultó un donante de esperma que engendró 15 hijos
Dramático engaño: el terrible secreto que ocultó un donante de esperma que engendró 15 hijos
Dramático engaño: el terrible secreto que ocultó un donante de esperma que engendró 15 hijos
T13 En Vivo
Un aviso a través de redes sociales para mujeres que buscaban donantes de esperma para tener hijos terminó en un dramático engaño.
El británico James MacDougall, de 37 años, posteó su ofrecimiento, anunciando donaciones privadas en internet sabiendo que su condición le impediría ir a una clínica.
Y es que MacDougall sufre el síndrome del cromosoma X frágil, una condición genética incurable y que deriva en un coeficiente intelectual bajo y retraso en el desarrollo, según publicó The Sun.
Más allá de la buena voluntad que decía tener, y de su aparente inocencia, el hombre ocultó esta información a las mujeres, lo que tuvo un fuerte impacto en los 15 niños que nacieron producto de sus donaciones de esperma.
Pero eso no es todo. A pesar de que en un comienzo firmó un documento en el que aseguraba que no quería tener contacto con los menores, acudió al Tribunal de Familia para pedir que ordenaran a las mujeres darle tiempo con cuatro de los niños, todos menores de 3 años, para ejercer su paternidad.
Según Nathalie Lieven, la jueza a cargo del caso, MacDougall le entregó un documento afirmando que no tendría derechos sobre el niño, ni derecho a contactarlo. Además, al final del escrito de tres hojas, aseguraba que tenía el síndrome X frágil, pero sin explicar de qué se trataba.
De acuerdo con la publicación del periódico, la madre, de 25 años, quien tiene problemas para leer y es extremadamente vulnerable, dijo que no analizó en detalle el acuerdo, según contó la magistrada Lieven, quien además solicitó revelar el nombre de MacDougall para que ninguna otra mujer tenga hijos con él.
Después de dar a luz, la madre se puso en contacto con el sujeto, quien incluso vivió en la casa de ella durante los primeros meses de la pandemia, antes de que la mujer le pidiera que se fuera, en junio de 2020.
Al mencionar las causas, ella aseguró que él le hizo comentarios sexuales y también se duchó con el niño pequeño en al menos dos oportunidades, lo que consideró extremadamente inapropiado, según detalló The Sun.

¿Qué tiene que ver Henry Cavill? Los rumores de Shakira y Piqué que transformaron al actor en viral
En un primer momento el hombre se alejó, pero luego regresó y finalmente fue arrestado por atacarla y dejarla con moretones en el cuello y la espalda.
Finalmente, MacDougall fue acusado de aprovecharse del deseo de las mujeres de tener hijos, sin preocuparse por el impacto que podría tener en las madres y los niños.
The Mirror añade que el hombre tenía dificultades de aprendizaje y estaba en el espectro autista, con una profunda falta de perspicacia, según determinó la jueza.
A su favor, la madre adoptiva de MacDougall, June, contó que su hijo es “bondadoso, pero crédulo”.
“Él quería ser parte de sus vidas, quería ver a sus hijos. Él sólo quería ayudar a esas personas, ayudar a esas mujeres lesbianas a cumplir sus sueños y convertirse en madres. No buscó ningún dinero, hasta donde sabemos, por brindar ese servicio, simplemente lo hizo”, publicó The Mirror.










